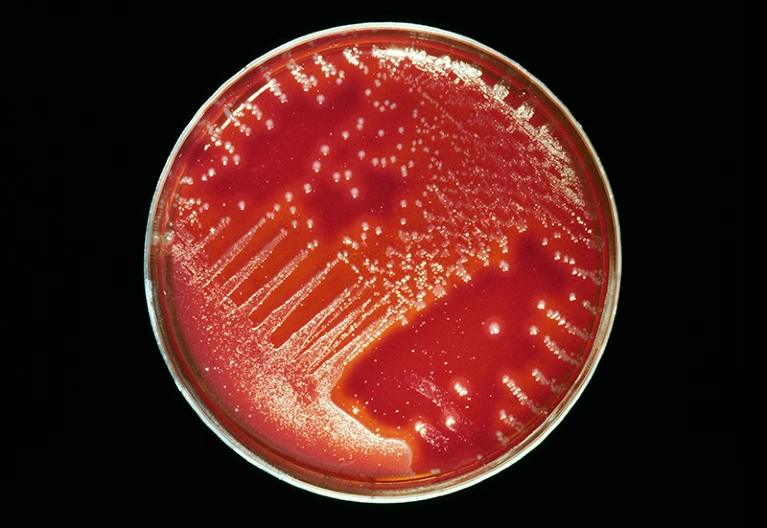

News Feed
Heads up, parents…here’s what you need to know to protect your kids…
https://www.youtube.com/watch?v=3R6I6JI26ZA
Surreal experience…
https://www.youtube.com/watch?v=ij0VUU6L1io